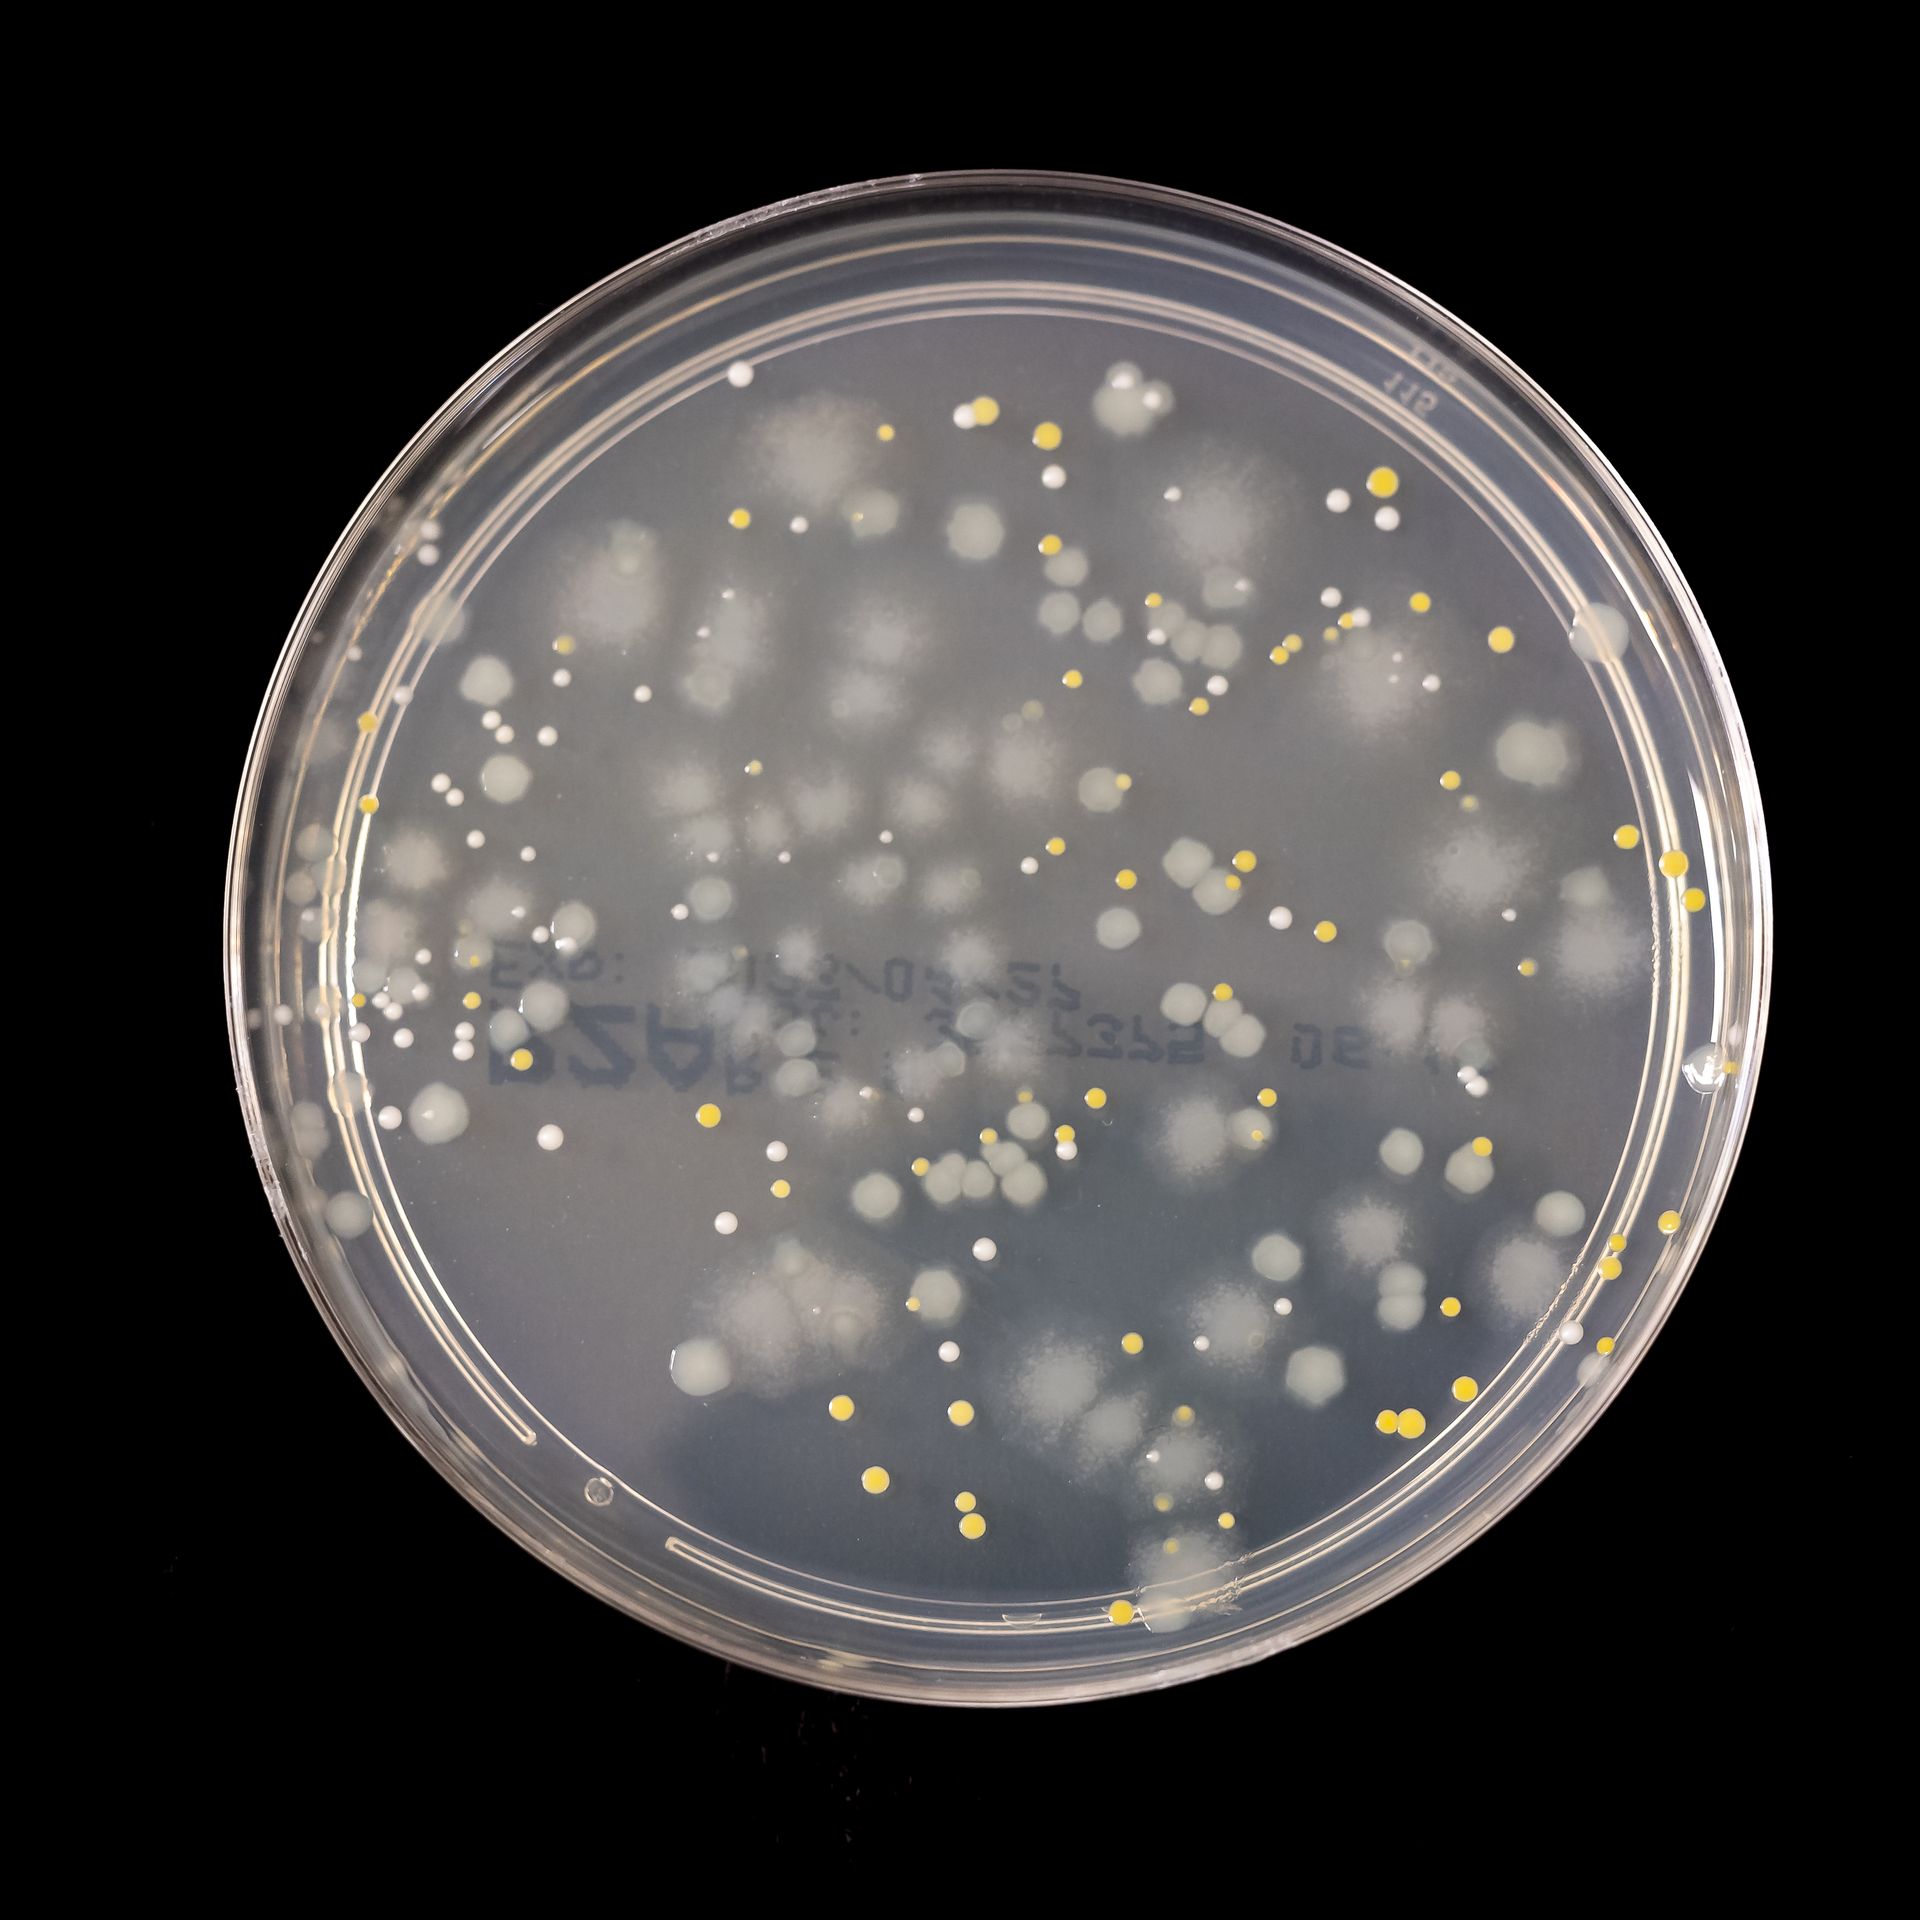
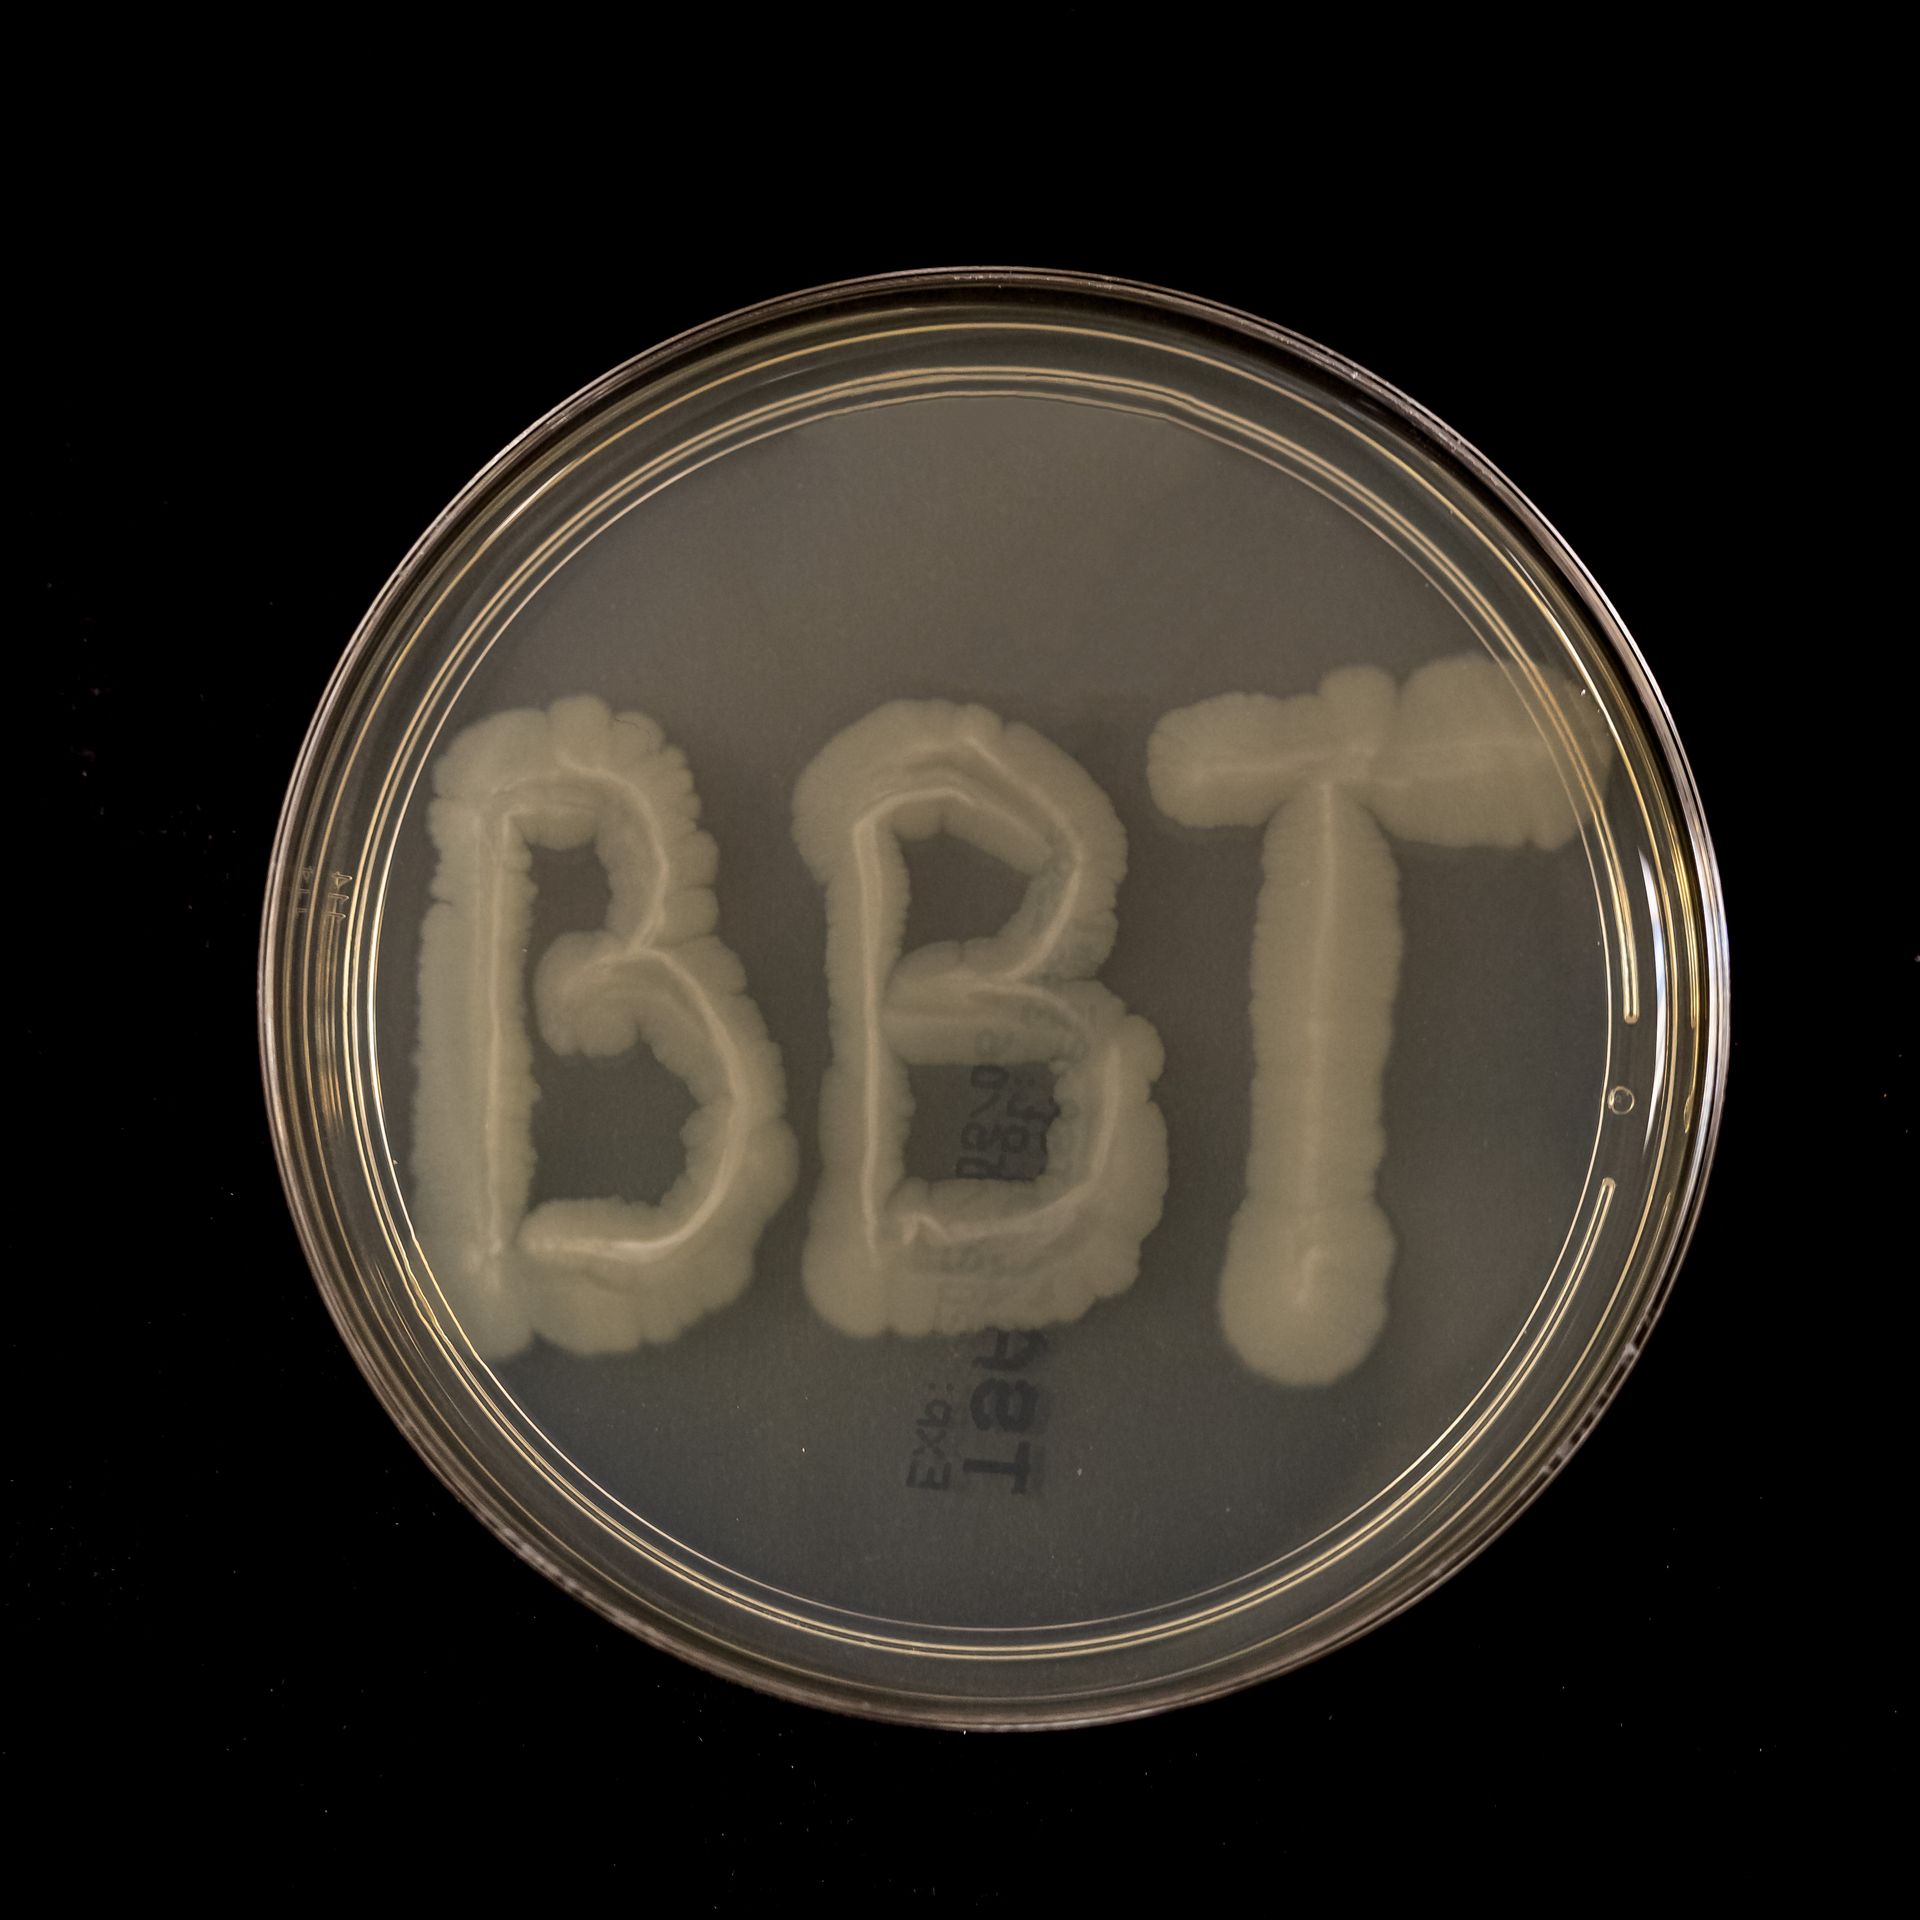

Galerie – Einblick in unsere Events & Teambuilding
In unserer Galerie erhalten Sie einen Eindruck von unseren Events – von stimmungsvollen Weihnachtsfeiern bis hin zu inspirierenden Teambuilding-Aktivitäten. Wir legen großen Wert auf ein starkes Miteinander und schaffen Erlebnisse, die verbinden.